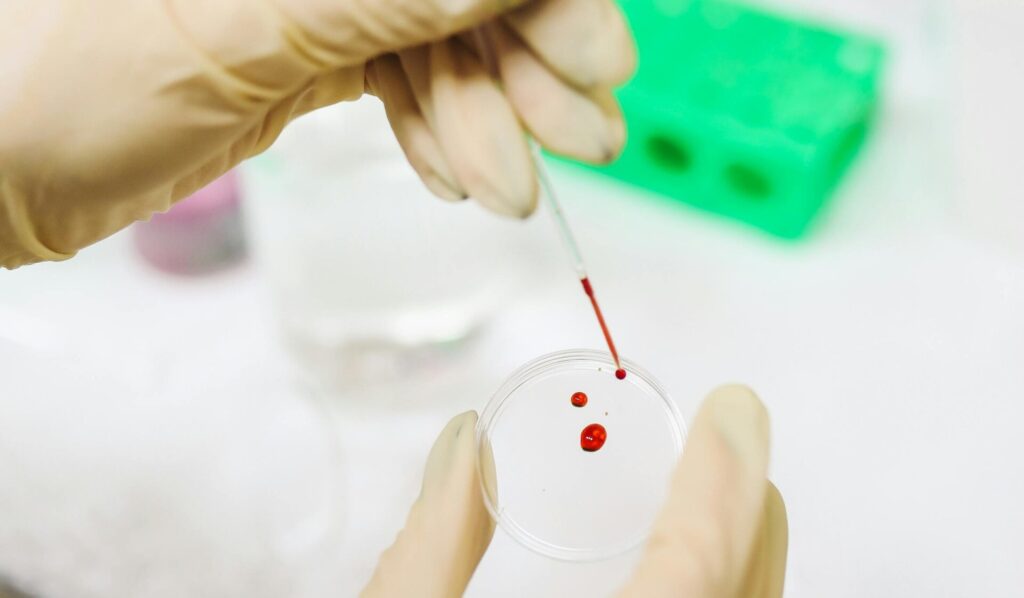
mecfs biomarker

Long Covid
ME CFS Ratgeber Deutsch 2025: Der umfassende Leitfaden
Ein Teil der Long COVID Betroffenen entwickelt ME/CFS – eine schwere multisystemische Erkrankung, die das Leben grundlegend verändert. Dieser Ratgeber gibt Ihnen einen ersten Überblick über ME/CFS und zeigt, welche Strategien wirklich helfen.

Neueste Kommentare